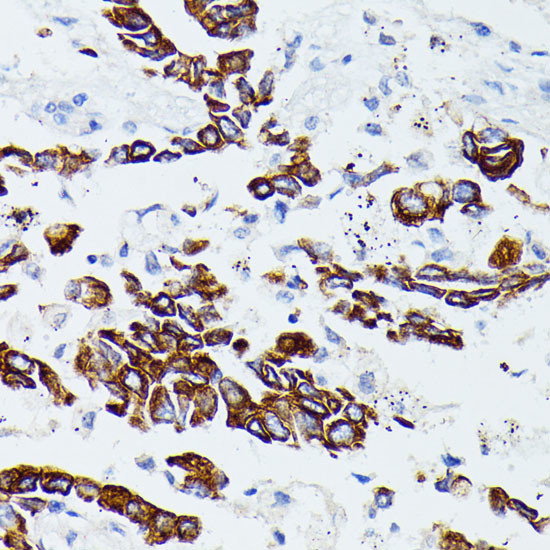
MMP25 Antibody in Immunohistochemistry (Paraffin) (IHC (P))

Search
Invitrogen
MMP25 Polyclonal Antibody
{{$productOrderCtrl.translations['antibody.pdp.commerceCard.promotion.promotions']}}
{{$productOrderCtrl.translations['antibody.pdp.commerceCard.promotion.viewpromo']}}
{{$productOrderCtrl.translations['antibody.pdp.commerceCard.promotion.promocode']}}: {{promo.promoCode}} {{promo.promoTitle}} {{promo.promoDescription}}. {{$productOrderCtrl.translations['antibody.pdp.commerceCard.promotion.learnmore']}}
图: 1 / 4
MMP25 Antibody (PA5-76690) in IHC (P)




Please note: We are reviewing Western blot images included in the antibody testing data in our catalog, including those provided by third parties. Unless expressly labeled or annotated as “raw-unedited”, Western blot images included in the antibody testing data in our catalog may have been edited, optimized or otherwise adjusted for presentation.
产品信息
PA5-76690
种属反应
已发表种属
宿主/亚型
分类
类型
抗原
偶联物
形式
浓度
规格
纯化类型
保存液
内含物
保存条件
运输条件
RRID
产品详细信息
The antibody was affinity-purified from rabbit antiserum by affinity-chromatography using epitope-specific immunogen and the purity is > 95% (by SDS-PAGE).
靶标信息
Proteins of the matrix metalloproteinase (MMP) family are involved in the breakdown of extracellular matrix in normal physiological processes, such as embryonic development, reproduction, and tissue remodeling, as well as in disease processes, such as arthritis and metastasis. Most MMPs are secreted as inactive proproteins which are activated when cleaved by extracellular proteinases. However, the protein encoded by this gene is a member of the membrane-type MMP (MT-MMP) subfamily, attached to the plasma membrane via a glycosylphosphatidyl inositol anchor. In response to bacterial infection or inflammation, the encoded protein is thought to inactivate alpha-1 proteinase inhibitor, a major tissue protectant against proteolytic enzymes released by activated neutrophils, facilitating the transendothelial migration of neutrophils to inflammatory sites. The encoded protein may also play a role in tumor invasion and metastasis through activation of MMP2. The gene has previously been referred to as MMP20 but has been renamed MMP25.
仅用于科研。不用于诊断过程。未经明确授权不得转售。
生物信息学
蛋白别名: Leukolysin; matrix metallo protease; matrix metallopeptidase 25; matrix metalloproteinase 25; Matrix metalloproteinase-25; Membrane-type matrix metalloproteinase 6; Membrane-type-6 matrix metalloproteinase; MMP; MMP 25; MMP-25; MMPs; MT MMP 6; MT-MMP 6; MT6 MMP; MT6-MMP
基因别名: F730048C11Rik; Leukolysin; MMP20; MMP25; MMPL1; MT6-MMP; MT6MMP
UniProt ID: (Mouse) Q3U435
Entrez Gene ID: (Rat) 302963, (Mouse) 240047